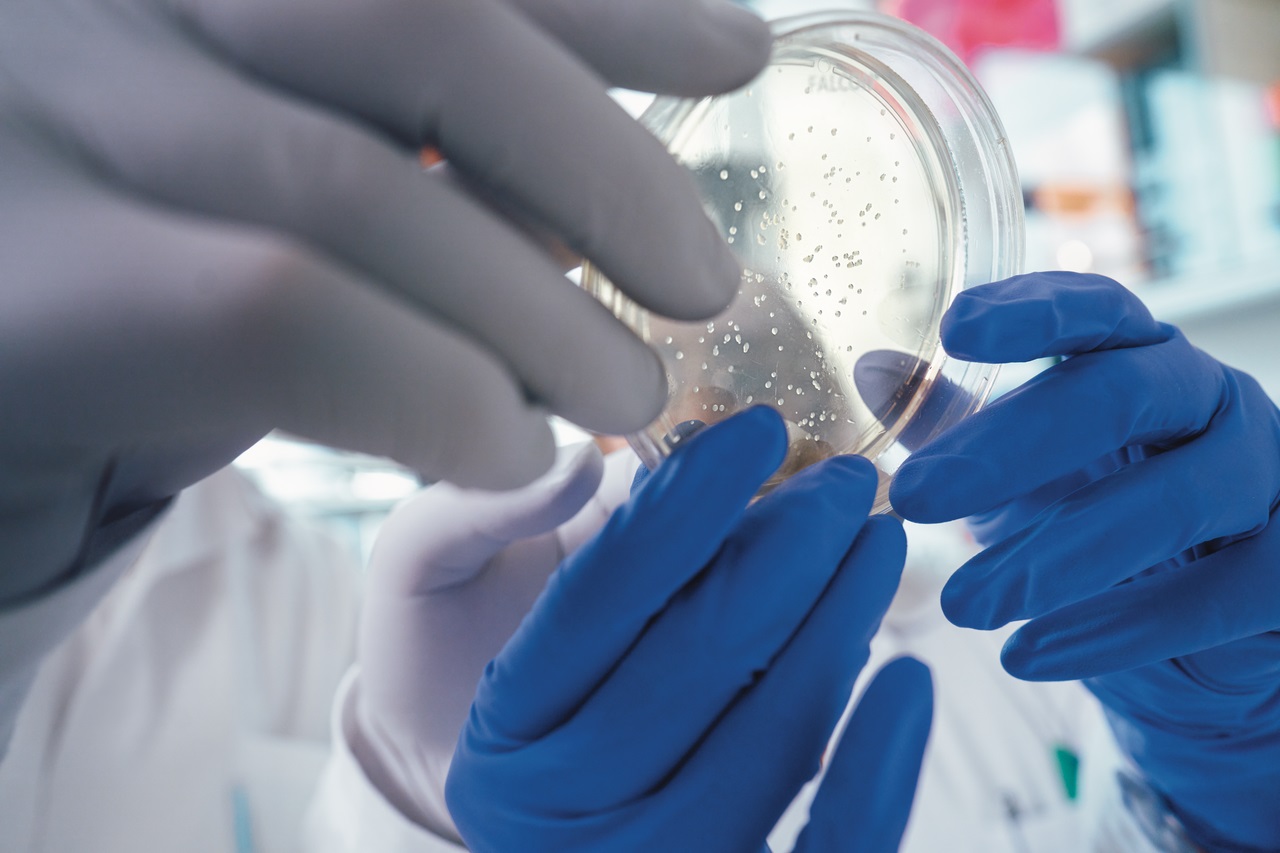

Making sustainable medicines through eco-design
Ensuring the health of our planet is an integral part of our purpose to transform lives for generations. Environmental degradation not only exacerbates existing health issues, but also creates new challenges. For this reason, one component of our sustainability strategy is to minimize the environmental footprint of our medicines by reducing energy, water consumption, carbon footprint and waste. To achieve this, we have begun to integrate eco-design principles across the medicine's entire lifecycle. Our ambition is that by 2030, 100% of our R&D projects and products will apply the principles of eco-design and green chemistry.
The ‘Eco-design Playbook’: A step towards a holistic integration of eco-design in drug development
Eco-design aims to integrate environmental aspects into product design and development with the goal of reducing the environmental footprint throughout all stages of a medicine’s lifecycle. Green chemistry is a component of eco-design. One of its principles aims to minimize waste and the use and generation of hazardous substances in the development of chemical products1. These approaches give us not only the opportunity to protect the environment but also maximize efficiencies and reduce production timelines and costs. To make eco-design part of our culture and daily business, we’ve created the ‘Eco-design Playbook’: a checklist of eco-design parameters that we evaluate for every project at pre-defined milestones during drug development of small molecules and biologics.

“We’ve been active in the field of Green Chemistry for over 10 years. This gained expertise was instrumental in our journey to sustainable medicine development through holistic eco-design. This encompasses the raw materials for making the drug substance, the drug product, the device and packaging, all the way to distribution of the medicine, patient use and end-of-life” says Frank Roschangar, Highly Distinguished Research Fellow from Development Sciences, Innovation Unit Sustainability at Boehringer Ingelheim. “We have also built significant know-how in the implementation of eco-design in biologics development – we developed and applied advanced molecular and bioreactor modeling tools to intensity our manufacturing processes to increase productivity, reduce resource consumption and a lower environmental footprint.” He adds.

Blazing the trail: The first advanced green chemistry metric
A key barrier to eco-design and eco-friendly medicines is the absence of transparent and comparable eco-assessments. Thus, pharmaceutical companies face difficulties in evaluating and improving the sustainability of their medicines. In 2014, Boehringer Ingelheim introduced the Green Aspiration Level (GAL), which was the first greenness standard for active pharmaceutical ingredient (API) manufacturing 2. We then teamed up with 13 companies from 2 consortia and 2 universities to lead the evolution of this metric: the innovation Green Aspiration Level 2.0 (iGAL) 3.
The iGAL enables the assessment of the greenness of a process (performance), and the quantification of improvements of greenness (sustainable innovation). It also measures how much waste was eliminated, linking the achievements of scientists and companies to the United Nations Sustainable Development Goal 12, which is to “ensure sustainable consumption and production patterns” 4.
API manufacturing generates a considerable amount of waste, representing both an environmental and an economic challenge, as waste correlates to production costs 5. Processes with poor environmental performance can be quickly identified via the iGAL and proactively improved early in product development. The tool can also facilitate benchmarking and tracking of environmental performance over time, potentially inspiring companies to develop eco-friendlier products and helping promote sustainable practices in healthcare.
“This metric is a huge leap forward, since it enables greater transparency and the much-needed comparability between different APIs. Still, more standards are needed to cover the rest of the lifecycle and the overall product,” Roschangar says.
Roschangar is leading our efforts in fostering the metric through collaboration with the International Consortium for Innovation & Quality in Pharmaceutical Development (Green Chemistry working group) and the American Chemistry Society Green Chemistry Institute Pharmaceutical Roundtable – in which about 30% of member companies already adopted the iGAL metric.
“It is our goal to support establishing necessary industry standards, which we can only do by working together with industry partners, academia, and government. We are among the forefront and can help move the entire industry towards more sustainable medicines.” adds Roschangar.
Powering eco-design with open innovation on opnMe.com
To accelerate our learning curve towards more sustainable medicines, we aim to encourage external innovation through our open innovation portal opnMe.com under the umbrella of the ‘More Green Grants’ program. Here, our researchers from all functions involved in the process of inventing, developing, and producing a medicine propose pre-competitive sustainability challenges within the field of eco-design with the potential to minimize the environmental footprint of our medicines. These challenges are then shared externally through our webpage opnMe.com, which enables us to identify leading experts from academia and industry and encourages them to submit their innovative ideas and solutions. The selected project receives an $80,000 grant for a 12-month research collaboration. Learn more about opnMe.com.
The initial challenge was launched in November 2022 and received 34 proposals from 17 countries. Boehringer Ingelheim promotes the open science principle and intends not to patent the identified solutions, but rather publish and share them across the scientific community, pharmaceutical and allied industries, and thereby help drive global sustainability practices forward for the benefit of our planet and global health.
References
- (a) 12 Principles of Green Chemistry - American Chemical Society. https://www.acs.org/greenchemistry/principles/12-principles-of-green-chemistry.html. (b) Anastas, P. T., Warner, J. C. Green Chemistry: Theory and Practice, Oxford University Press: New York, 1998, p.30.
- Roschangar, F., Sheldon, R. A. & Senanayake, C. H. Overcoming barriers to green chemistry in the pharmaceutical industry-the Green Aspiration LevelTM concept. Green Chem. 17, 752–768 (2015).
- Roschangar, F., Li, J. et al. Improved iGAL 2.0 Metric Empowers Pharmaceutical Scientists to Make Meaningful Contributions to United Nations Sustainable Development Goal ACS Sustainable Chem. Eng., 2022, 10, 5148–5162.
- United Nations Sustainable Development Goal 12. https://sdgs.un.org/goals/goal12.
- Normalized production cost versus cumulative waste observed at Bristol-Myers Squibb, in Li, J., Eastgate, M. D. Making Better Decisions during Synthetic Route Design: Leveraging Prediction to Achieve Greenness-by-Design. React. Chem. Eng. 2019, 4 (9), 1595
Related Content

Digital innovation: „We change the way labs work“
Our innovation strategy: putting the patient first


